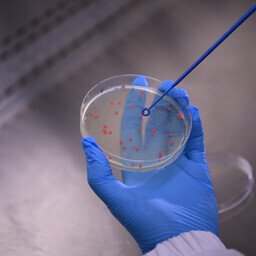

Liigu peamenüü juurde 24.04.26 TEHNIKA ... Euroopa tuumauuringute keskuse CERN-i Suures Tuumaosakeste Põrgutis Genfi lähedal maa-aluses rõngastunnelis on väikesi aineosakesi suure hooga põrkuma pannud füüsikud märganud võimalikke pisikesi kõrvalekaldeid osakeste standardmudeli teoreetilistest ennustustest, mis võivad osutada, et standardmudel sisaldab vastuolusid ja tuleb asendada millegi muuga.
17.04.26 ÜHISKOND ... Eesti e-riigi tugevus on ametnike oskus kriisidest kärmelt õppida. Tartu Ülikoolis kaitstud doktoritööst selgub, et viimaste kümnendite ohuolukorrad andsid riigi kaitsevõime arengule varjatud hoo.
17.04.26 TEHNIKA ... Möödunud nädalal tegi Artemis II missiooni meeskond edukalt tiiru ümber Kuu ja inimjalg võiks NASA plaanide järgi Kuule astuda aga 2028. aasta alguses. Eesti ekspertide hinnangul on ootus üleliia optimistlik, sest alles arendatavaid maandumismooduleid ootavad esmalt tuleristsed Maa orbiidil ja USA heitlik poliitika toob ajakavasse katkestusi.
16.04.26 TEHNIKA ... Käsikäes tehisaru pealetungiga kasutavad haigladki üha enam sellel põhinevaid insuldi- ja diabeedimudeleid. Austraalia teadlased leidsid, et enam kui sajas taoliste mudelite alustalaks olevas teadustöös on kasutatud kahtlast päritolu andmeid. Nende enda uuring pole aga veel pälvinud teiste teadlaste sõltumatut hinnangut.
14.04.26 TEHNIKA ... Lõuna-California Ülikooli teadlased lõid uudse mäluseadme, mis töötab tõrgeteta 700-kraadises kuumuses. Kuigi lahendusest võiks kasu olla nii kosmosemissioonidel kui ka tehisaru energiatarbe vähendamisel, nõuab täisväärtusliku kiibi loomine veel tõsist arendustööd.
09.04.26 TEHNIKA ... Tartu Ülikoolis kaitstud doktoritöö näitas, et eestikeelseid tehisintellekti mudeleid saab arendada ka väheste andmetega, kui kasutada mitmekeelset siirdeõpet.
09.04.26 TEHNIKA ... Teaduses on kombeks kõike, mida saab, mõõta ja kaaluda, et võimalikult täpselt tuvastada kõikvõimalikke mõõdetavaid ja kaalutavaid tõsiasju meie maailma kohta.
06.04.26 TEHNIKA ... Kuigi Eesti tekstiili- ja rõivatööstus on ajas kahanenud, siis selle tähtsus tuli esile koroonakriisis, mil ilmnes, et Euroopas ei suudetud toota piisavalt meditsiinilisi maske. Sestap on teadlase sõnul valdkonna arendamine strateegiliselt oluline, et olla valmis uuteks võimalikeks kriisideks.
02.04.26 TEHNIKA ... Kvanttehnoloogia kiire areng on toonud lähemale ka võimaluse muukida lahti praegu internetiliiklust turvavad krüpteerimisalgoritmid. Hiljutine uuring vihjab, et mitmeid taolisi algoritme saab mõistliku aja jooksul lahti muukida juba ligikaudu 10 000 kvantbitist koosneva arvutiga.
01.04.26 TEHNIKA ... Miljonid inimesed otsivad tervisemuredele lahendust tehisarult, kuid värske uuringu kohaselt annab tavaline veebiotsing sageli paremaid tulemusi.
01.04.26 TEHNIKA ... Mida enam kübersüsteemid levivad, seda tähtsamaks saab küberturvalisus. Turvalisus on tähtis, aga kohati ka tüütu: meeles tuleb pidada salasõnu, esitleda tuleb sõrmejälgi või vikerkesta.
27.03.26 TEHNIKA ... Eesti akuelementide inseneri osalusel valminud töö osutab, et juba olemasolevaid tehnilisi lahendusi optimeerides on võimalik kasvatada liitiumioonakude laadimistsüklite arvu üle 30 000. Teisisõnu oleks võimalik kiiret tühjenemist kartmata teha ühe ja sama akuga ümber planeedi elektriautoga 300 tiiru.
25.03.26 TEHNIKA ... Šveitsis asuva Cern-i osakestefüüsika labori teadlased sõidutasid esmakordselt antiainet hoidva seadme veokiga teaduslinnaku ühest otsast teise. Ajalooline katse avab ukse antiosakeste jagamisele teiste Euroopa laboritega.
25.03.26 LOODUS ... Jaapani teadlaste 20 aastat kestnud katse näitas, et vähemalt hiiri ei saa lõputult kloonida, sest 58. põlvkonnas viisid kuhjunud geenivead liini kuhtumiseni. Katse tõestas, et imetajaliigid püsivad elujõulised vaid siis, kui nad paljunevad loomulikul teel.
24.03.26 TEHNIKA ... Möödunud aasta lõpus lakkasid paljud veebilehed ja platvormid töötamast: selle taga oli tõrge Cloudflare'i sisu turvalise edastamise rahvusvahelise teenuse töös. Väiksema ulatusega rikkeid on tekkinud hiljemgi. Küberturvalisuse ekspertide hinnangul ilmestavad vahejuhtumid interneti jätkuva tsentraliseerumisega seotud riske.
24.03.26 LOODUS ... Taime saagikust saab osaliselt mõjutada selle õhulõhede kaudu. Seni on neid taime ainevahetust korraldavaid pilusid uuritud eeskätt müürloogal. Nüüd näitasid Eesti taimeteadlased geenmuundatud odra näitel, et aretuses väärivad tähelepanu samad õhulõhede tööd juhtivad valgud.
23.03.26 TEHNIKA ... Nii tugevaid gravitatsioonilaineid, mida on üldse lootust mõõta ja märgata, tekib ainult kõige võimsamais kosmilisis plahvatusis. Mõõtmise ja märkamise jaoks on seejuures tarvis kilomeetrite pikkust seadet, mida nimetatakse laserinterferomeetriks.
18.03.26 TEHNIKA ... Füüsikud avastasid Suurest Tuumaosakeste Põrgutist ennenägematu ja erakordselt raske aineosakese. Osake koosnes ühest kergest ja kahest raskest aine ehituskivist ning lagunes väga kiiresti.
18.03.26 TEHNIKA ... Veebruari keskpaigas lahvatanud kokkupõrge tehnoloogiahiiu Anthropicu ja USA valitsuse vahel on märgilise tähendusega pretsedent ning tõstatab eetilisi ja õiguslikke küsimusi tehisaru kasutamise üle riigikaitses, osutavad eksperdid.
17.03.26 TEHNIKA ... Praegu disainitakse kodusid, aga ka neis leiduvaid esemeid lõplike toodetena ja inimkeskselt. Tartu Ülikoolis kaitstud doktoritöö autor pakub aga välja tööriista, millega luua kodude asemel tähendusrikkamaid eluruume. Taolised ruumid teeksid elanikust aktiivse ja loomingulise kaaskujundaja.
16.03.26 TEHNIKA ... Ameerika materjaliteadlased on töötanud välja ülijuhi, mis toimib normaalse õhurõhu käes rekordiliselt kõrgel temperatuuril.
13.03.26 TERVIS ... Inimesed erinevad üksteisest palju muu hulgas oma ajutöö poolest. Sestap tuleks psühhiaatrilise vaevuse diagnoosimiseks jälgida iga inimese ajulaineid pika aja jooksul. Tallinna Tehnikaülikoolis kaitstud doktoritöö autor leidis nüüd mõõdikud, millele inimeste erinevusest hoolimata tähelepanu pöörata.
12.03.26 TEHNIKA ... Tartu Ülikooli ja ettevõtte BiotaTec teadlased leidsid viisi, kuidas eraldada vanadest trükkplaatidest baktereid appi võttes väärtuslikke metalle. Erinevalt paljudest varasematest sarnastest katsetest toimis protsess hästi ka suuremal skaalal, kirjutab Tartu Ülikooli biokeemia kaasprofessor Priit Jõers.
12.03.26 TEHNIKA ... Rühm Saksa teadlasi suutis esimest korda ajaloos taastada peale selle sügavkülmutamist täiskasvanud hiire ajukoe normaalne elektriline aktiivsus. Kui ajulõikudes õnnestus säilitada isegi õppimisvõime, on terve aju külmutamiseni veel pikk tee minna.
10.03.26 TEHNIKA ... Hiiglaslik andmekeskus kasvatab märgatavalt Eesti elektritarbimist. Sellel võib aga olla positiivne mõju teistele tarbijatele.
10.03.26 TEHNIKA ... Tehisaru kiire areng vallandab peagi uue tööstusrevolutsiooni. Kuna masinad võtavad rutiinsed ülesanded üle, ohustab see Euroopas ja Ameerika Ühendriikides sadu miljoneid töökohti. Küberjulgeoleku ekspert Lauri Almanni sõnul põhjalike teadmistega inimesed oma töö kadumist kartma ei pea.
09.03.26 TEHNIKA ... Kes meist ei oleks valanud tühjakssaavast piimapakist piima või tühjakssaavast oliiviõlipudelist õli, oodates kärsitult või kannatlikult, millal väljub kõige-kõige viimane tilgake väärtuslikku vedelikku!
08.03.26 TEHNIKA ... ERR-i teadusuudiste portaali Novaatori eksperiment näitas, et suurkorporatsioonide keelemudelid ei ole eesti keele nüanssidega kursis. Juturobotitele eestikeelsete andmete jagamine tõstatab aga hulga kriitilisi küsimusi autoriõiguste ning andmekaitse kohta.
06.03.26 TEHNIKA ... Ehkki tehisaru teeb üha rohkem inimeste elu mõjutavaid otsuseid, ei suuda see neid alati inimesele arusaadavalt põhjendada. Tartu Ülikoolis kaitstud doktoritöö osutab, et inimesed ootavad masinalt realistlikke ja usaldusväärselt mõjuvaid seletusi.
03.03.26 TEHNIKA ... Korvpallimängu ajal kostub üle saali pidevalt kõva kriuksumist ja vilinat. Häälte taga on korvpalliketside tallamustri iseärasused, leidis rahvusvaheline teadlasrühm. Ühtlasi on ketside kriuksumisel füüsikalises mõttes mõndagi ühist maavärinate tekkega.
02.03.26 TEHNIKA ... Tänapäeva kiirmood on teinud elu mugavamaks ja lõbusamaks, kuid selle võrra on hoogsamalt kerkima hakanud ka tekstiilijäätmete kuhjad. Euroopa Liidus tekib aastas ligi 12 miljonit tonni tekstiiliprügi, millest ringlusse jõuab vaid viiendik.
27.02.26 TEHNIKA ... Põlde ja katuseid katvate ränipõhiste päikesepaneelide võidukäigu taustal jätkub laborites arendustöö alternatiivide kallal, mis võivad osutuda pikas plaanis odavamaks ning energiasäästlikumaks. Tallinna Tehnikaülikoolis (TTÜ) kaitstud doktoritöö annab nüüd parema pildi püriidil ehk kassikullal põhinevate päikesepaneelide pindmisest kihist, astudes sellega väikese sammu lähemale nende Kuul tootmisele.
27.02.26 TERVIS ... Tehisintellekt (TI) on Eesti haiglates muutunud asendamatuks abiliseks nii insuldi- kui ka kiiritusravis, hoides kokku tunde arstide väärtuslikku aega. Samas toob uus tehnoloogia kaasa valehäireid ja lisakohustusi, põrkudes omakorda kokku e-riigi andmesegadusega.
26.02.26 TEHNIKA ... Ühismeedias levivast valeinfost jõuab märkimisväärne osa meieni pahaaimamatute tavakasutajate kaudu. Tallinna Ülikooli teadlased töötasid välja uue liigitussüsteemi, mis aitab tulevikus tehisintellektil eristada teadlikke manipulaatoreid inimestest, kes jagavad eksitavat sisu puhtast teadmatusest.
26.02.26 TEHNIKA ... Baktereid hävitavad pinnakatted, mis tunduvad esmapilgul väga tõhusad, võivad aja möödudes alt vedada, selgus Tartu Ülikooli teadlaste uuringust. Seepärast on parimate antibakteriaalsete materjalide loomiseks vaja teha pikemaajalisi katsed.
26.02.26 TEHNIKA ... Kui hambaarst paneb mõnele hambale uue plommi, võib see tunduda hetkega kivikõva. Tartu Ülikooli teadlaste värske uuring näitab aga, et näiliselt tahkes materjalis jätkub molekulide liikumine ka pärast kõvastumist ja just see võib mõjutada, kui kaua hambatäidis vastu peab.
22.02.26 TEHNIKA ... Maaülikooli jõudis Eesti ainus soolestikumasin, mis simuleerib kõiki protsesse, mis meie seedesüsteemis toimuvad. Teadlased plaanivad sellega testida toidu kõrvalsaadustest saadavaid tervisele kasulikke ühendeid, näiteks kiudained, et oleks võimalik teada saada, kuidas need mõjuvad meie soolestiku bakteritele.
19.02.26 TEHNIKA ... Microsofti teadlased esitlesid uut andmesalvestussüsteemi, mis kirjutab info laseriga tavalise klaasi sisse. Kuigi meetod võimaldab talletada infot erinevalt praegustest salvestusviisidest vähemalt 10 000 aastat, piirab selle rakendusvõimalusi aeglane kirjutamiskiirus.
19.02.26 TEHNIKA ... Suur osa jäätmeid on bioloogilist päritolu ja sobivad seega bakteritele toiduks. Tartu Ülikooli materjaliteadlane valmistas oma doktoritöö käigus mikroobidele hüdrogeelist n-ö 3D-trükitud hotellid. Seal saavad nad elada, talitleda ja selle käigus jäätmeid väärindada, ilma et väliskeskkond neid segama tuleks.
18.02.26 TEHNIKA ... KBFI vanemteaduri Joosep Pata eestvedamisel loodud uus tehisarupõhine meetod suudab töödelda osakestefüüsika andmeid praegustest standardprogrammidest kümneid kordi kiiremini. Algoritm pakub sellega lahendust tulevikus hüppeliselt kasvavate andmehulkade analüüsiks.
18.02.26 TEHNIKA ... Novaator küsis viie populaarsema keelemudeli käest eesti keelt ja kultuuri puudutavaid küsimusi ning koostas vastuste põhjal pingerea. Kõige terasemaid vastuseid andis Grok, kuid eesti teadlased on rahul ka spetsiaalselt eestikeelsel materjalil treenitud mudeli tulemustega.
17.02.26 TEHNIKA ... Ühismeedia kohta võib rääkida head ja halba, ja võib hellitada mõtet see koolilastele ka täiesti ära keelata. Aga loodusteadusele ja looduskaitsele võib ühismeediast olla üllatavalt palju kasu.
12.02.26 TEHNIKA ... Juhita sõitvaid busse näeb Eestis praegu ainult teaduskatsete ajal või ajutistel lühiliinidel. Tallinna Tehnikaülikoolis kaitstud doktoritöö osutab, et inimeste hirmu mehitamata sõiduki ees aitab maandada isiklik reisikogemus. Isejuhtivate busside laiemat kasutust toetaksid ka rangem testimine, paremad andurid ja ühtlustatud suhtlusreeglid sõitjatega.
06.02.26 TEHNIKA ... Hiina teadlased saatsid põimunud aatomitel rajanevat kvantkrüptograafiat kasutades andmeid 11 kilomeetri kaugusele. Saavutus aitab tuua kvanttehnoloogilist lahendust laborist argiellu ja on seega suur samm häkkimiskindla interneti suunas.
06.02.26 ÜHISKOND ... Tundeid nagu viha või hirmu saab teatud sõnadega väljendada, ent teistega esile kutsuda. Navarra Ülikooli professor Ruth Breeze suudab arvutilingvistikat kasutades sellised sõnad tekstist üles leida ja nende sageduse ära mõõta. Nii tuleb ilmsiks, kes poliitikutest püüab rahva hääli viha õhutades ja kes hirmu külvates.
05.02.26 TEADUSELU ... Loodusteaduste valdkonnas riikliku teaduspreemia pälvinud Tartu Ülikooli kolloid- ja keskkonnakeemia professor Kaido Tammeveski töörühm tahab kütuseelementides asendada haruldase plaatina odavama rauaga ja muuta keskkonnasäästliku transpordi kättesaadavamaks.
05.02.26 TEHNIKA ... Tartu Ülikooli füüsika instituudi teadlased töötasid välja uue viisi kolmemõõtmeliste piltide kvaliteedi parandamiseks. See võimaldab arvutusliku kuva meetoditega suurendada hologrammide teravussügavust ehk fookuses olevat osa tagantjärele kuni viis korda.
05.02.26 TEHNIKA ... Punast värvi pärm, mida seni on tuntud eeskätt õlide ja pigmentide tootjana, võib tulevikus aidata asendada naftapõhiseid materjale.
04.02.26 TEHNIKA ... Maailma laevastik on viimase 20 aastaga pea kahekordistunud ning peaaegu sama tempokalt on kasvanud vaatamata kaasaegsele tehnikale õnnetuste arv. Tallinna Tehnikaülikooli professori Pentti Kujala osalusel valminud uuring näitab, et praegused ohutusmudelid on liiga jäigad ega suuda arvestada merel valitseva määramatusega.
02.02.26 TEHNIKA ... Haruldaste muldmetallidest on saanud riikliku julgeoleku nurgakivi. Euroopa ja Eesti strateegilist sõltumatust Hiinast pärsivad killustunud regulatsioonid ja poolik tootmisahel, mis sunnib ka siinse toorme lõplikuks väärindamiseks ikkagi Aasiasse saatma, leiab keemia- ja metallurgiatööstuse insener Jane Paju.